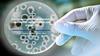
Бактериальная загрязненность школьных предметов и рук учащихся

Similar presentations:
Гигиена рук- залог здоровья
1. Исследовательская работа на тему: Гигиена рук- залог здоровья
:Выполнили работу:
Ученицы класса М-9-2
Никифорова Евгения
Ейкова Анна
2. Введение
В настоящее время многие люди задаются вопросами:обязательно ли мыть руки перед едой? После улицы? После
туалета? Причем большинство из них относятся к своему
здоровью халатно и безразлично. Мы думаем, что это
неправильно. Ведь гигиена рук также играет важную роль в образе
жизни человека. Гигиена рук – самая важная мера,
позволяющая избежать передачу потенциально вредных
микроорганизмов. Мы решили проверить, сколько процентов детей
в нашей школе соблюдают здоровье своих рук, серьезно ли
относятся к различным недостаткам своей кожи на руках.
Также мы исследовали смывы с рук после долгого рабочего дня
через наномикроскоп и обнаружили на нем 1 из видов бактерий.
Ходили в санэпидемстанцию, чтобы более подробно изучить
состав смыва.
Всемирный день мытья рук, простой процедуры, помогающей
избавиться от "вредных" микробов, отмечают 15 октября. В тоже
время известно, что среди сотен бактерий, "обитающих" на коже
здорового человека, есть и "полезные" бактерии
3. Цели и задачи
Выяснить загрязнение рук учащихся и соблюдение правил гигиеныучениками лицея
4. Ход работы
Прочитали литературу на данную тему;Наблюдали за учащимися лицея перед посещением в столовую,
после посещения туалета;
Провели анкетирование среди учащихся лицея;
Сопоставили результаты анкетирования с наблюдением;
Изучение смыва с руки после дневного пребывания в школе с
помощью наномикроскопа;
Установили, какие бактерии содержатся на руке с помощью
микробиологической лаборатории;
Пришли к общему выводу
5. Обзор литературы
Вопрос гигиены не может быть проблемой одного человека.Помимо его желания он может стать распространителем
тяжелых заболеваний в кругу семьи, близкие и родные
находятся вблизи «грязнули» в опасности. Кишечные
инфекции способны поразить сразу все семейство, а не
одного человека. Во время эпидемий множество людей
избежали заболеваний именно потому, что вовремя и
регулярно мыли руки. Нам известны достоверные сведения
относительно того, какой эффект производит на микробов
простое действие – мытье рук. Микробы погибают в течение
10 минут, если их поместить на чистую кожу рук.
Заболевания, которые могут возникнуть из-за неправильной
гигиены рук: грипп, кишечные инфекции, глисты
6. Результаты анкетирования
Как обычно вы моете руки? С мылом или без него?С мылом:43человека
Без мыла:57 человек
Моете ли вы руки перед едой?
Да:90человек
Нет:10 человек
7.
Моете ли вы руки послепосещения туалета?
Да:52человека
Иногда:32 человека
Нет:16 человек
Как часто вы моете руки?
8. Результаты наблюдения
Общее количество учащихся перед походом в столовую: 100человек
Из них помыли руки без мыла:10
Помыли руки с мылом:20
Вообще не мыли руки:70
9.
Общее количество учащихся, моющих руки после похода втуалет: 100 человек
Из них помыли руки без мыла:30
Помыли руки с мылом: 20
Вообще не мыли руки:50
10. Исследование
Для исследования поверхностей объектов окружающей среды намикробную загрязненность использовали метод смывов. С
помощью метода смывов можно определить присутствие искомого
микроорганизма или количество микроорганизмов в расчете на
1мл. На данном опыте мы убедились, что бактерии на руках
действительно есть Используя определитель Берджи, мы узнали,
какие бактерии находятся на снимках. Это стрептококки.
11. Процесс исследования
12.
Далее мы взяли смывы с окружающих объектов . Смывыбыли отправлены в микробиологическую лабораторию, где
проводились дальнейшие их исследования. Количество
колоний микробов много (2000 КОЕ/мл) только в тряпке для
вытирания доски, а в школьных принадлежностях и
телефонах учеников (30 КОЕ/мл) в 66 раз меньше микробов.
Объекты
№/№
Общее микробное
число (КОЕ/мл)
1
Дверная ручка
200
2
Тряпка у доски
2000
3
Телефон ученика
10
4
Телефон ученика
10
5
Телефон ученика
10
6
Парта №1 у окна каб 21
2,1
7
Школьные принадлежности ученика
30
8
Школьные принадлежности ученика
90
9
Подоконник
410
10
Учительский стол
250
13. Вывод
1)Выяснилось, что по-настоящему руки моют лишь единицы, хотяпо результатам анкетирования показалось, что все стараются
следить за своим здоровьем. Но это не так. Дети, даже осознавая
свои ошибки продолжают их совершать.
2)Необходимо обязательно мыть руки перед едой, после
посещения туалета, после прихода с улицы, после общения с
животными, так как на них скапливается множество бактерий.
Необходимо соблюдать личную гигиену, так как грязные руки – один
из легких способов попадания бактерий в наш организм;
3) Из объектов окружающей среды, которые мы исследовали,
больше всего бактерий было на тряпке у доски, подоконнике,
учительском столе и дверной ручке













 medicine
medicine life safety
life safety